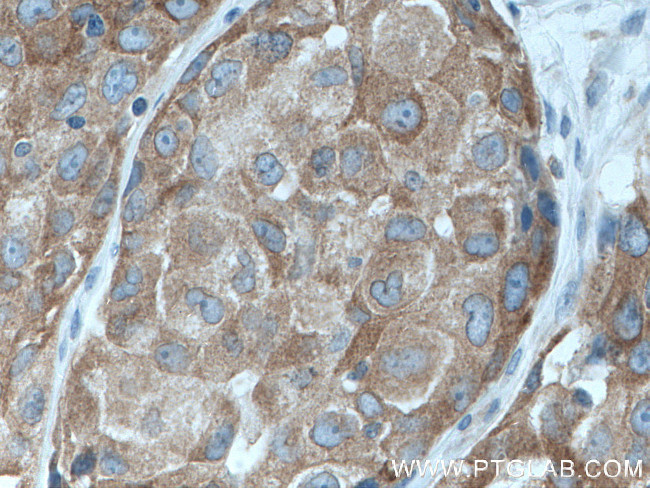
IRAK1 Antibody in Immunohistochemistry (Paraffin) (IHC (P))

Search
Proteintech
IRAK1 Monoclonal Antibody (1H10A7)
{{$productOrderCtrl.translations['antibody.pdp.commerceCard.promotion.promotions']}}
{{$productOrderCtrl.translations['antibody.pdp.commerceCard.promotion.viewpromo']}}
{{$productOrderCtrl.translations['antibody.pdp.commerceCard.promotion.promocode']}}: {{promo.promoCode}} {{promo.promoTitle}} {{promo.promoDescription}}. {{$productOrderCtrl.translations['antibody.pdp.commerceCard.promotion.learnmore']}}
产品信息
66653-1-IG
种属反应
宿主/亚型
分类
类型
克隆号
抗原
偶联物
形式
浓度
纯化类型
保存液
内含物
保存条件
运输条件
产品详细信息
Immunogen sequence: GQRAVKTHG ARTKYLVYER LEKLQAVVAG VPGHLEAASC IPPSPQENSY VSSTGRAHSG AAPWQPLAAP SGASAQAAEQ LQRGPNQPVE SDESLGGLSA ALRSWHLTPS CPLDPAPLRE AGCPQGDTAG ESSWGSGPGS RPTAVEGLAL GSSASSSSEP PQIIINPARQ KMVQKLALYE DGALDSLQLL SSSSLPGLGL EQDRQGPEES DEFQS (420-633 aa encoded by BC014963)
靶标信息
IL-1 receptor associated kinases (IRAKs) are serine/threonine kinases involved in signaling via Toll/IL-1 pathways. It is rapidly recruited by MYD88 to the receptor-signaling complex upon TLR activation. IRAK's association with MYD88 leads to IRAK1 phosphorylation by IRAK4 and subsequent autophosphorylation and kinase activation. Alternatively, IRAK1 can phosphorylate TIRAP to promote its ubiquitination and subsequent degradation. IRAK1 also phosphorylates the interferon regulatory factor 7 (IRF7) to induce its activation and translocation to the nucleus. This results in the transcriptional activiation of type I IFN genes, which drive the cell in an antiviral state.
仅用于科研。不用于诊断过程。未经明确授权不得转售。
生物信息学
蛋白别名: Interleukin-1 receptor-associated kinase 1; IRAK-1; Pelle homolog
基因别名: IRAK; IRAK1; pelle
UniProt ID: (Human) P51617
Entrez Gene ID: (Human) 3654